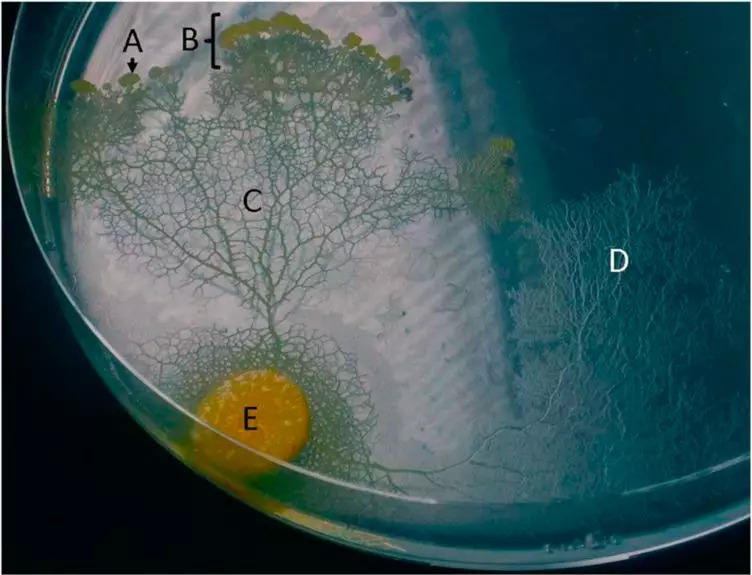

文|中国科普博览
近日,法国一家动物园展出一种特别的生物,外表像真菌、行为像动物的有机体。没有嘴、没有眼睛但是却找到食物,没有大脑但是“学习”走迷宫却不费劲。更神奇的是,即使把它切成两半,短时间之内还能“自愈”,简直就是显示版的“毒液”既视感。
这种神奇的生物其实是黏菌。其实黏菌在现实生活中并不难见,只是多数时候不太容易查觉。因为它们的生活方式与习惯跟真菌差不多,喜欢阴暗、潮湿的环境中,黏菌曾一度被划到真菌界。现在科学家知道,黏菌跟阿米巴虫关系更近,现在被划到变形虫界,跟真菌界是并列的一支。

生命树,黏菌介于动植界、真菌之间,是一个“异类”。(图片来源www.google.com)

黏菌图片(图片来源:www.google.com)
Part.1、挑战走迷宫?让这些无脑生物设计铁路网也没问题
其实这不是黏菌第一次火起来,黏菌早就因为其独特的解迷宫的能力在网上火过。把黏菌放在迷宫的入口,把一食物放在出口,不久就会发现,黏菌似乎能很容易“找”到出口。这易操作、易观察的实验极大地刺激了人们的好奇心,黏菌被用来解各种各样的迷宫,很少让人失望过。

黏菌解迷宫。(图片来源www.google.ocm)
这种能力也被科学家早早地注意到。日本科学家曾发表一篇研究,在培养皿里让黏菌绘制了东京铁路系统的线路图。
科学家把东京部分等比例缩小到培养皿中,然后在培养皿上对应东京附近重要的地铁站的36个位置放上食物,用黏菌避光的特性,用光斑模拟海岸线和地形,这样黏菌能组合出不同路径的路线来连接食物。
要知道,连接起这36个点的方案可以说是无穷无尽的,东京铁路线路经许多年、许多人的打磨也变成世界上最成熟、高效的铁路线路,但黏菌不消多久就能走出连接食物的线路,其中有些跟人类花费巨大人力与智力设计的世界上最成熟的地铁线路拟合度很高。
科学家们似乎也玩得乐此不疲,想知道黏菌的极限到底在哪里,甚至还有科学家利用黏菌找食物的能力去拟合全球的丝绸之路路线。

黏菌利用原质团“找”到连接食物最短的路径。(图片来源:参考文献[1])


黏菌拟合的铁路路线。(图片来源:参考文献[2])
没有大脑、甚至没有眼睛,为什么黏菌能做这么复杂的工作呢?其中的诀窍其实很简单。
黏菌并没有一开始就算出最简单的路径,它采用的是穷举法,靠伸出去的原质体进行大面积全方位的搜索,利用化学物质标记每条路径,然后只保留其中传输效率最高的路径来连接食物,其余的路径就“放弃”掉,毕竟这样能最大化地利用食物,增加自己的觅食效率,因此它的记忆能力更像是反复试错的结果。
对每一种生命来说,食物是关键。在演化这场历时悠久的旅途中,每个生命的寻找食物的技能都得到了充分的打磨,才得到我们今天叹为观止的展现。
黏菌回避已经探索过的无效路径(图D)。(图片来源:参考文献[3])
Part.2、720种性别?给黏菌设计厕所好难
处于营养期时的黏菌是一个单细胞的变形虫态,靠延伸的原质体去到处寻找食物。但是,饥饿会触发黏菌聚集,进入繁殖期,在潮湿、阴暗的环境会触发黏菌形成子实体。子实体由孢囊与孢囊柄组成,孢囊里产生的就是孢子——黏菌后代。

黏菌的生活史。(图片来源www.google.com)
网上所说的黏菌有720种“性别”就来源于孢囊里能产生不同类型的孢子,实际上这跟性别的定性有些差距。黏菌是同配生殖,单细胞的孢子没有明显形态与大小上的差距,也就是说没有性别之间的分化,也就是说只能称之为不同的交配型(mating types)。
其720种性别的说法来源于其产生的孢子有不同的基因型,已经有研究的跟“性别”差异相关的基因有好几个,每个又有不同的变型,组合起来,“性别”就多了。

黏菌的不同交配型,只是基因层面的差异。(图片来源:参考文献[4])
但实际上,不同的黏菌其实交配类型差别很大,与“性别分化的相关基因也有些不同。
而且其“性别”分化机制没有完全弄清,可以说,我们对黏菌还所知甚少,说黏菌有720种性别其实是不严谨的。
但是可以肯定的是,黏菌作为单细胞生物,其不同性别之间的性状分化没有人类的那么复杂,其恶劣环境下触发的有性生殖(比如饥饿),并产生的多“性别”的机制也很贴合“性”的本质。其多样的性别为“两性”之间的结合提供了更多可能性,这样不同“性”之间积累的变异可以相互组合,产生更适合环境的下一代。
这种能力某种程度上也是生命的必备技能之一,毕竟生活的地球是一个多变的环境,只有保持后代的多样性才不至于在多变的环境中全军覆没。
Part.3、想养黏菌该怎么操作?在线等,挺急的
其实黏菌火了之后,在国外甚至连接了一个社区,饲养黏菌、交换黏菌、分享黏菌一步步吞噬食物的视频,去感悟其生活,模拟黏菌的生存智慧,带来的启示意义与社会链接已经超过基本的生物学知识了。
去哪领?黏菌本身不难找,喜欢的阴湿的环境。在潮湿的森林,翻开腐烂的木头,也许就能找到,甚至它还会从家里的木质地板里忽然冒出来。当然,现在饲养黏菌的人也不少,找到熟人分享一下也可以。

在野外,腐烂木头上忽然爆发的多头绒泡菌。(图片来源:www.google.com)
怎么喂食?黏菌算比较容易养的生物。大多数黏菌是腐生菌,大家常养的是多头绒泡菌,吃的食物也不是很挑剔,如果要喂养的话,喂燕麦片是个不错的选择。
看着黏菌从一个小角落探出来,慢慢流动把食物吃光,不去思考它本身的生存智慧,光看着就挺解压的。

黏菌“脉动”起来去寻找食物。(图片来源:www.google.com)
当然,了解得越多后,我们本身也不用太惊讶于黏菌的功能。毕竟每个生活在地球上的生命,关于爱与希望(生存与繁衍)都有自己独到的解答。毕竟这是生命的所有意义,有多复杂、多绚丽、多闻所未闻都不足为奇。
哪怕只是一个单细胞的生命,也经过了亿万年的生存之旅,每一种生物随着我们对它们了解得更多,就会发现我们对于生命这个让地球充满活力与秘密的奇迹还所知甚少。
参考文献:
[1]Nakagaki, Toshiyuki. "Smart behavior of true slime mold in a labyrinth." Research in Microbiology152.9 (2001): 767-770.
[2] Tero, Atsushi, et al. "Rules for biologically inspired adaptive network design." Science327.5964 (2010): 439-442.
[3]Reid, Chris R., et al. "Slime mold uses an externalized spatial “memory” to navigate in complex environments." Proceedings of the National Academy of Sciences109.43 (2012): 17490-17494.
[4] Bloomfield, Gareth, et al. "Sex determination in the social amoeba Dictyostelium discoideum." Science330.6010 (2010): 1533-1536.
[5]Urushihara, Hideko, and Tetsuya Muramoto. "Genes involved in Dictyostelium discoideum sexual reproduction."European journal of cell biology85.9-10 (2006): 961-968.
出品:科普中国
制作:廖鑫凤 、卢宪雯、史鸣明、杨莲(昆明植物研究所国家植物博物馆展陈专项办公室)
监制:中国科学院计算机网络信息中心
(本文中标明来源的图片已获得授权)
本文来源于”中国科普博览“公众号(kepubolan),转载请注明公众号出处

